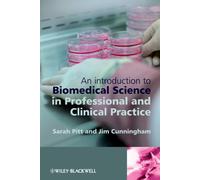
An Introduction to Biomedical Science in Professional and Clinical Practice

£38.99
amazon.co.uk
Free Delivery

The Handy Clark's positioning in Radiography: An easily accessible guide in radiographic/anatomy positionings and procedures, plus basic pathology ... books and Expert Radiography Practices)
£9.76
amazon.co.uk
Delivery from £2.99

£79.06
Amazon-marketplace.co.uk
Delivery from £7.74

Robbins & Kumar Basic Pathology
£64.59
Whsmith.co.uk
Free Delivery

Histology and Cell Biology: An Introduction to Pathology
£47.53
Amazon-marketplace.co.uk
Free Delivery

2025-2026 Basic and Clinical Science Course, Section 4 : Ophthalmic Pathology and Intraocular Tumors
£157.70
Whsmith.co.uk
Free Delivery

£60.27
Amazon-marketplace.co.uk
Delivery from £2.80

Dual Pathology : Recommendations for Improving the Quality of Care
£33.24
Whsmith.co.uk
Free Delivery

Brain Anatomical Model, Stroke Cerebral Hemorrhage Cerebral Arteriovenous Malformation Brain Pathology Teaching Models for Neurology Medical Teaching Aid.
£46.94
Amazon-marketplace.co.uk
Free Delivery
An Introduction to Biomedical Science in Professional and Clinical Practice
£37.95
Whsmith.co.uk
Free Delivery

Histology and Cell Biology, An Introduction to Pathology: With STUDENT CONSULT Online Access
£71.22
Amazon-marketplace.co.uk
Free Delivery

Crash Course Pathology
£30.39
Whsmith.co.uk
Free Delivery

The Eye : Basic Sciences in Practice
£86.44
Whsmith.co.uk
Free Delivery

Dual Pathology : Recommendations for Improving the Quality of Care
£147.25
Whsmith.co.uk
Free Delivery

Oxford Handbook of Pathology
£35.14
Whsmith.co.uk
Free Delivery

Robbins and Cotran Pathology Flash Cards
£27.99
Whsmith.co.uk
Free Delivery

Murray's Basic Medical Microbiology : Foundations and Clinical Cases
£30.39
Whsmith.co.uk
Free Delivery

ORAL AND MAXILLOFACIAL SURGERY : An Illustrated Guide for Medical Students and Allied Healthcare Professionals
£14.25
Whsmith.co.uk
Delivery from £3.99

Treatment Resource Manual for Speech-Language Pathology
£144.00
Whsmith.co.uk
Free Delivery

Junqueira's Basic Histology: Text and Atlas, Seventeenth Edition
£73.14
Whsmith.co.uk
Free Delivery

Embryology : An Essential Textbook
£76.00
Whsmith.co.uk
Free Delivery

Interpreting Musculoskeletal Images : Anatomy, Pathology and Emergency Reporting
£33.24
Whsmith.co.uk
Free Delivery

Pulmonary Physiology and Pathophysiology : An Integrated, Case-Based Approach
£56.04
Whsmith.co.uk
Free Delivery

Anatomy, Physiology, and Pathology Workbook : Study Tools, Practices, and Exercises for Students to Understand the Human Body
£16.14
Whsmith.co.uk
Delivery from £3.99

Wheater's Pathology: A Text, Atlas and Review of Histopathology
£52.24
Whsmith.co.uk
Free Delivery

Boorman's Pathology of the Rat : Reference and Atlas
£217.54
Whsmith.co.uk
Free Delivery
🤖 Ask ChatGPT
🛍️ What are the most important purchase criteria?
💰 Tell me the best deals!
📋 Create a short summary!
Informations about "basic pathology: an"
Compare 49 offers for your search.
Pricehunter was able to locate products in 21 categories, ranging from £9.76 to £217.54.
About "basic pathology: an"
- In total, Pricehunter was able to locate 3 offers, from providers such as Amazon-marketplace.co.uk, Whsmith.co.uk and amazon.co.uk.
- After having chosen your supplier you may also choose the delivery company. 4 delivery companies are available Elsevier, Taylor & Francis Group, Oxford University Press and McGraw-Hill Education being the most popular.
- The most offers (3) were found in the price range from £47.00 to £47.99.
- Customers who looked for this item also found interesting.
- With our extensive colour palette you can select your favourite colour for your article. Of the available 0 shades is the most frequently chosen.
Don't forget your voucher code:
Report Illegal Concerns
You are about to report a violation based on the EU Digital Services Act (DSA).